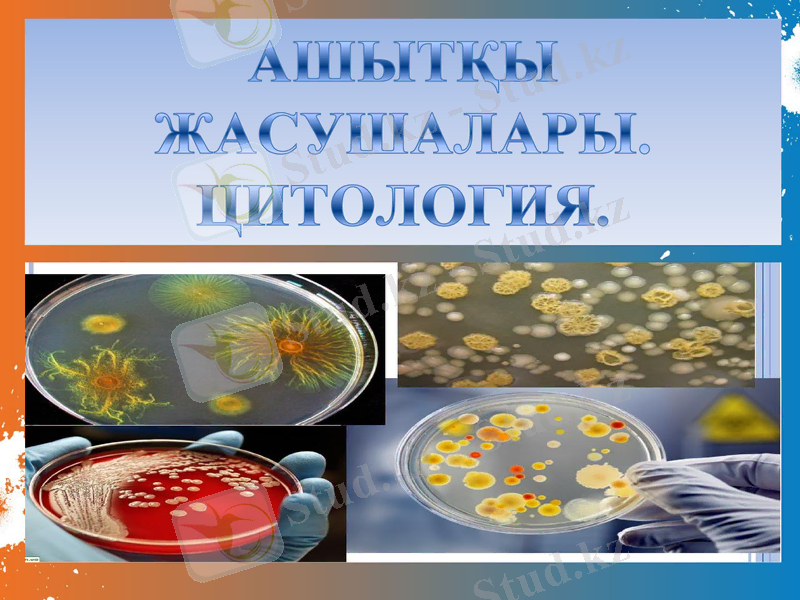
Slide 1

Ашытқы жасушалары: цитология, құрылымы, жіктелуі және химиялық құрамы

АШЫТҚЫ ЖАСУШАЛАРЫ.
ЦИТОЛОГИЯ.

ЖОСПАР:
1. КІРІСПЕ;
2. АШЫТҚЫ ЖАСУШАЛАР ТУРАЛЫ;
3. АШЫТҚЫ ЖАСУШАЛАР ҚҰРЫЛЫСЫ, ЖІКТЕЛУІ;
4. ҚҰРЫЛЫМЫ. МОРФОЛОГИЯСЫ;
5. АШЫТҚЫ ЖАСУШАЛАРДЫҢ ХИМИЯЛЫҚ ҚҰРАМЫ;
6. ЦИТОЛОГИЯ;
ПАЙДАЛАНЫЛҒАН ӘДЕБИЕТТЕР;

КІРІСПЕ:
Ашытқы жасушалары дегеніміз бүршіктенетін немесе бөлінетін бір жасушалы саңырауқұлақ, өлшемдері бойынша микро ағза болып табылады. Микроағзалар алғаш рет ХVII ғ. ортрасында Левенгук ашқан еді. Қазіргі түсініктер бойынша ашытқылар жеткілікті дәрежеде бір жасушалы ағза болып табылады. Ашытқы өндірісі кептірілген және пірестелген ашытқылар өндіреді. Негізінен ашытқыларды наубайхана, кондитер, консерві өндірістерінде қолданылады. Сонымен қатар, ашытқыларды дәрумен өндіру өндірісінде Д және В2 алу үшін, медицина саласында емдік препараттар, нуклейн қышқылдарын, түрлі ферменттерді алу үшін микробиология саласында қоректік орта дайындау үшін, ауыл шаруашылығында жас малдарды өсіруге, құс фермалары мен балық шаруашылығында кеңінен қолданылады.

Ашытқы жасушалар. Қантты ашыту үшін спирт өнеркәсібінде Saccharamyces cerevisiol түріндегі ашытқыларды қолданады. Осындай типтегі бір - бірінен кейбір белгілері бойынша ерекшеленетін бірнеше түрлі жасушалар пайдаланылады. Дән, картоп шикізатын қайта өңдейтін спирт зауыттарында мальтоза, сахароза, фруктоза жақсы ашытатын, бірақ соңғысы декстринді ашытпайтын ашытқыларды қолданады.

Ашытқы саңырауқұлақтары - бір клеткалы қозғалмайтын және бактериялардан шамамен алғанда он еседей ірі микроорганизмдер. Табиғатта кең тараған. Жасуша пішіні әртүрлі: дөңгелек, сопақша және таяқша тәрізді болады. Ашытқы саңырауқұлақтары жасушасының мөлшері 8-10 микронға тең . Оларда қозғалу органеллалары болмайды. Жасуша сыртында қабығы бар. Цитоплазмада ядро, ваколя және басқа да (май, гликоген, валютин) заттары кездеседі. Ашытқы саңырауқұлағын адам қолдан өсіріп, өз шаруашылығында пайдаланады. Ал, табиғатта жабайы ашытқы саңырауқұлақтары да болады. Олар ауылшаруашылық өнімдерін зақымдап, едәуір зиянын тигізеді. Ашытқы саңырауқұлағының адам баласына пайда келтіретін түрлерін біз мәдени ашытқы саңырауқұлақтары деп атаймыз. Ашытқы саңырауқұлақтары өнеркәсіпте кең қолданылады. Олар қантты ашытып, көмірқышқыл газы мен спирт түзеді. Олардың бұл қасиеті нан ашытқы өндірісінде және спирт өндіруде, түрлі шараптарды, сыраларды, сүт тағамдарын даярлауда қолданылады. Ашытқы саңырауқұлақтарында ақуыз және витаминдер (В. Д. Е) көп болады, сондықтан оларды қазір тамақ және мал азығын алу мақсатында кеңінен қолданады. Ашытқы саңырауқұлағы көбінесе бүршіктену арқылы көбейеді. Бұлар спора түзу және жәй бөліну арқылы сирек көбейеді. Олардың кейбір түрлері жыныстық жолмен көбейеді. Бүршіктеніп көбейгенде, алдымен аналық жасушадан төмпешік пайда болады да, кейіннен ол үлкейіп бүршікке айналады. Одан кейін жас жасуша аналық организмнен мүлдем бөлініп кетеді. Қолайлы жағдайда бүршіктену екі сағатқа созылады. Көмірсу мен азотты қоректік затқа бай ортада ашытқы саңырауқұлағының бүршіктенуін жәй биологиялық микроскоптармен де көруге болады.

Ашытқы жасушалар құрылысы, жіктелуі
Ашытқылардың жіктелу негізінен олардың спора түзу қабілеттілігі жатады. Спора түзетін немесе түзбейтін, ашытқыға ұқсас саңырауқұлақтар. Спора түзетін және ашытқыға ұқсас саңырауқұлақтардың көбеуі. Sacchavomycetes классындағы бүршіктену арқылы көбейетін спора түзетін ашытқылар. Спора түзетін саңырауқұлақтар тұқымдастары: Sacchavomycetaclae, Sacchavomycodaceae, Schizosacchavomy cetaceae. Gziptococcaceae тұқымдас бүршіктенбейтін, ашытқылар және ашытқы тектес саңырауқұлақтар. Жемдік ашытқылар өндірісінде аспорогенді саңырауқұлақтарды қолдану. Наубайханалық ашытқылардың мәдениеттері мелассалық орталарға тұрақтылығы гинетакалық белсенділігін анықтайды., өсіру салыстырмалы жылдамдығына ие болу тиіс және құрамындағы ферменттер ß - фруктофура нозидаза және λ - глюкозидаза белсенді жоғары болады. Наубайханалық ашытқылардың жасушалары ірі, шаң-тозаңды болады. Наубайханалық ашытқыларды өндіру үшін келесі расалар мен штаммдар қолданылады: Толеская 7, ЛБД - 1, Одессалық 14, л - 441, А-1, киевтік 21, гибридті расалар.

ҚҰРЫЛЫМЫ. МОРФОЛОГИЯСЫ
Ашытқы жасушасы қабықтан, мембранадан және цитоплазмадан тұрады. Ашытқы жасушасы жасушалы қабырғадан, цитоплазмалық мембранадан, протоплазмадан, цитоплазмалық қосылыстар- митохондриядан, рибосомадан, ядродан, вакуоля және қоректік заттар волютин, гликоген, майлы тамшылардан тұрады. Жасушалы қабырға жасушаның негізгі құрылымдық элементі болып табылады. Қабырға қалыңдығы 1500-2500нм құрайды. Оның құрамына 90% көмірсулар 10% ақуыздар, липидтер, хитиннен тұрады. Орындайтын функциясы жасуша жасуша формасын бір қалыпты ұстап тұрады. Цитоплазмалық мембрана жасушалы қабырғадан кейін орналасады. Қалыңдығы 75-80нм, ақуыздармен липидтерден тұрады. Орындайтын функциясы жасушаның зат алмасуын реттейді.

Цитоплазма (протоплазма) жартылай сұйық фаза, негізінен коллойдтардан тұрады. Онда түрлі жасушалы құрылымдар орналасады-митохондриялар, ядро, қоректік заттар грануллалары, вакуолялар болады.

Рибосомалар-бұл ұсақ гранулалар олардың құрамына 58%ақуыз 42% рибонуклейн қышқылы (РНК) ақуызбен байланысқан түрінде болады. Бұл гранулаларда ақуыз синтезі жүреді. Бұларды ақуыз фабрикасы деп атайды.

Митохондрия- бұл бөліктер гранула немесе шыбықты жіпше түрінде болады. Олар ақуыздардан, липидтерден фосфолипидтерден, майлы қышқылдардан, ферменттер мен ДНК дан тұрады. Бұл бөліктер де энергиямен жасушаларды қамтамасыз ету процестер жүреді. Бұл бөліктерді жасушалардың энергетикалық цехтары деп атайды.

АШЫТҚЫ ЖАСУШАЛАРДЫҢ ХИМИЯЛЫҚ ҚҰРАМЫ
Ашытқылардың құрғақ заттары көміртегіден, сутегіден, оттегіден, азоттан және басқа да элементтерден тұрады. Ашытқылардың құрғақ заттардағы элементінің құрамы (%) ашытқылардың құрғақ заттары:ақуыздар және құрамында азот болатын заттар 50% майлар1, 6%, көмірсулар 33, 2%, клечатка 7, 6%, күл 7, 6% . Бірақ бұл құрам тұрақты емес және одан көп болуы мүмкін. Ашытқылардың құрамында азотболатын заттар негізінен ақуызбен(63, 8%) нуклеопротеидтермен(26, 1%) алеидтер және пептондар (10, 1%) көрсетілген, сонымен қатар құрамында: көміртегі 53%; сутегі 7, 1%; азот 15, 7, оттегі 22, 5% және фосфор 1, 7% болады.

Аминқышқылды құрамы ашытқылардың физиологиялық жағдайына тікелей байланысты. Құрғақ заттарға қарағанда азотты емес заттар 37% құрамды, оның ішінде 32-33% көмірсулар, 4-5% май. Көмірсулар полисахаридтер түрінде болады:гликоген, галоза, глюкан, хитин .

- Іс жүргізу
- Автоматтандыру, Техника
- Алғашқы әскери дайындық
- Астрономия
- Ауыл шаруашылығы
- Банк ісі
- Бизнесті бағалау
- Биология
- Бухгалтерлік іс
- Валеология
- Ветеринария
- География
- Геология, Геофизика, Геодезия
- Дін
- Ет, сүт, шарап өнімдері
- Жалпы тарих
- Жер кадастрі, Жылжымайтын мүлік
- Журналистика
- Информатика
- Кеден ісі
- Маркетинг
- Математика, Геометрия
- Медицина
- Мемлекеттік басқару
- Менеджмент
- Мұнай, Газ
- Мұрағат ісі
- Мәдениеттану
- ОБЖ (Основы безопасности жизнедеятельности)
- Педагогика
- Полиграфия
- Психология
- Салық
- Саясаттану
- Сақтандыру
- Сертификаттау, стандарттау
- Социология, Демография
- Спорт
- Статистика
- Тілтану, Филология
- Тарихи тұлғалар
- Тау-кен ісі
- Транспорт
- Туризм
- Физика
- Философия
- Халықаралық қатынастар
- Химия
- Экология, Қоршаған ортаны қорғау
- Экономика
- Экономикалық география
- Электротехника
- Қазақстан тарихы
- Қаржы
- Құрылыс
- Құқық, Криминалистика
- Әдебиет
- Өнер, музыка
- Өнеркәсіп, Өндіріс
Қазақ тілінде жазылған рефераттар, курстық жұмыстар, дипломдық жұмыстар бойынша біздің қор #1 болып табылады.



Ақпарат
Қосымша
Email: info@stud.kz